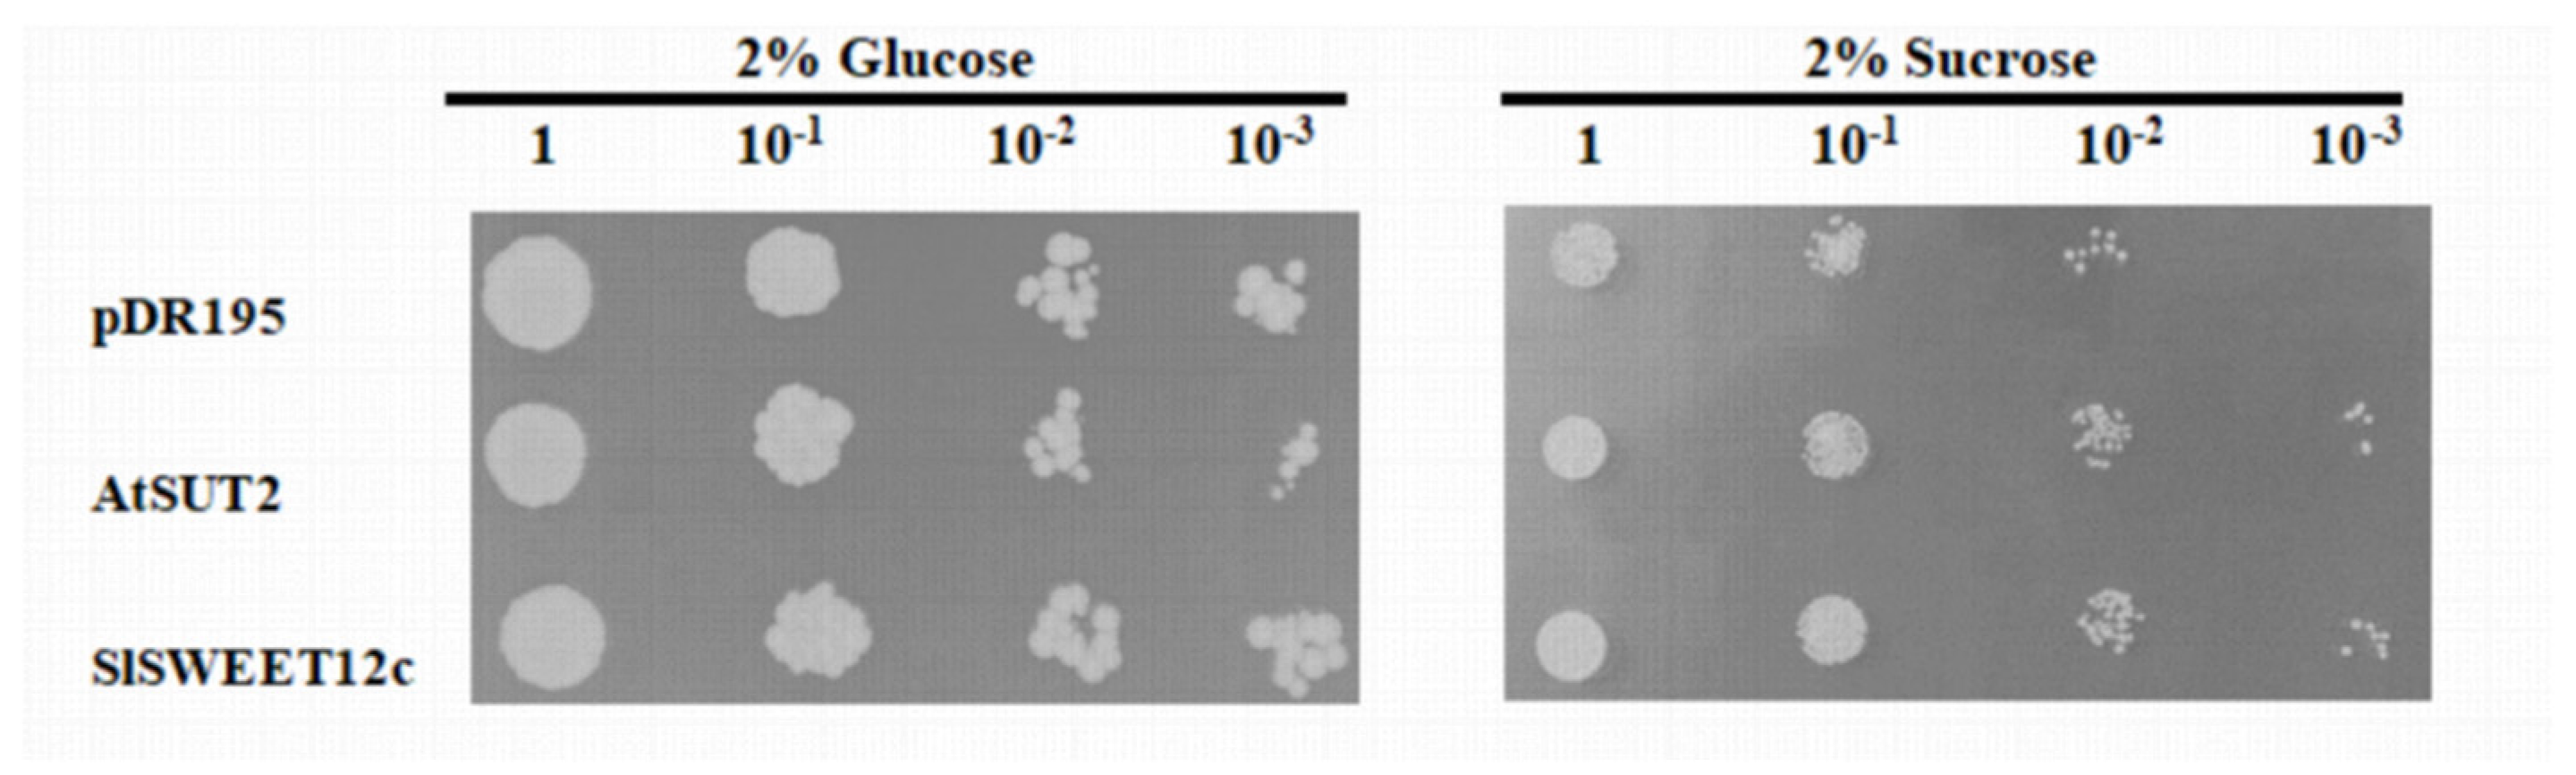
Horticulturae 08 00935 g004 Horticulturae 08 00935 g004

The SlSWEET12c Sugar Transporter Promotes Sucrose Unloading and Metabolism in Ripening Tomato Fruits
Abstract
1. Introduction
2. Materials and Methods
2.1. Expression of SlSWEET during Tomato Development
2.2. Plant Materials and Growth Conditions
2.3. RNA Extraction and Reverse Transcription-Quantitative Polymerase Chain Reaction (RT-qPCR)
2.4. Construction of SlSWEET12c-GUS Fusion Protein and Tomato Transformation
2.5. Subcellular Localization
2.6. RNA Interference (RNAi), Overexpression Vector Construction, and Plant Transformation
2.7. Functional Complementary Characterization of SlSWEET12c in Yeast
2.8. Sugar Content Measurement
2.9. Determination of Enzyme Activity Related to Sugar Metabolism
2.10. Statistical Analysis
3. Results
3.1. SlSWEET12c Is Highly Expressed in the RR Stage of Tomato Fruit
3.2. Histochemical Localization of SlSWEET12c
3.3. Subcellular Localization of SlSWEET12c
3.4. Transport Activity of SlSWEET12c in Yeast
3.5. Construction and Identification of Transgenic Plants
3.6. Soluble Sugar Content of SlSWEET12c Transgenic Plants in the RR Stage
3.7. Enzyme Activity of Sucrose Metabolism in SlSWEET12c Transgenic Plants
4. Discussion
4.1. Plasma Membrane-Localized SlSWEET12c Can Transport Sucrose, Glucose, and Fructose
4.2. SlSWEET12c May Be Involved in Sucrose Export during the RR Stage in Tomatoes
4.3. SlSWEET12c May Regulate Sugar Concentrations in the RR Fruit of Tomato
5. Conclusions
Supplementary Materials
Author Contributions
Funding
Institutional Review Board Statement
Informed Consent Statement
Data Availability Statement
Acknowledgments
Conflicts of Interest
References
- Kohji, Y.; Yuriko, O. Sugar compartmentation as an environmental stress adaptation strategy in plants. Semin. Cell Dev. Biol. 2017, 83, 106–114. [Google Scholar]
- Ru, L.; He, Y.; Zhu, Z.; Patrick, J.W.; Ruan, Y.-L. Integrating Sugar Metabolism with Transport: Elevation of Endogenous Cell Wall Invertase Activity Up-Regulates SlHT2 and SlSWEET12c Expression for Early Fruit Development in Tomato. Front. Genet. 2020, 11, 592596. [Google Scholar] [CrossRef] [PubMed]
- Stefan, R.; Masahito, A.; Tomohide, Y.; Haruko, M.; Koh, A.; Daisuke, S.; Katsuhiro, S. The sugar transporter inventory of tomato: Genome-wide identification and expression analysis. Plant Cell Physiol. 2014, 55, 1123–1141. [Google Scholar]
- Shammai, A.; Petreikov, M.; Yeselson, Y.; Faigenboim, A.; Moy-Komemi, M.; Cohen, S.; Cohen, D.; Besaulov, E.; Efrati, A.; Houminer, N.; et al. Natural genetic variation for expression of a SWEET transporter among wild species of Solanum lycopersicum (tomato) determines the hexose composition of ripening tomato fruit. Plant J. 2018, 96, 343–357. [Google Scholar] [CrossRef]
- Ho, L.-H.; Klemens, P.A.W.; Neuhaus, H.E.; Ko, H.-Y.; Hsieh, S.-Y.; Guo, W.-J. SlSWEET1a is involved in glucose import to young leaves in tomato plants. J. Exp. Bot. 2019, 70, 3241–3254. [Google Scholar] [CrossRef] [PubMed]
- Bresinsky, A.; Körner, C.; Kadereit, J.W.; Neuhaus, G.; Sonnewald, U. Strasburger’s Plant Sciences, Including Prokaryotes and Fungi; Springer: Berlin/Heidelberg, Germany, 2013; pp. 1065–1166. [Google Scholar]
- Ruan, Y.-L.; Patrick, J.W. The cellular pathway of postphloem sugar transport in developing tomato fruit. Planta 1995, 196, 434–444. [Google Scholar] [CrossRef]
- Patrick, J.W.; Offler, C.E. Post-sieve element transport of photoassimilates in sink regions. J. Exp. Bot. 1996, 47, 1165–1177. [Google Scholar] [CrossRef]
- Klee, H.J.; Giovannoni, J.J. Genetics and Control of Tomato Fruit Ripening and Quality Attributes. Annu. Rev. Genet. 2011, 45, 41–59. [Google Scholar] [CrossRef] [PubMed]
- Zanor, M.I.; Osorio, S.; Nunes-Nesi, A.; Carrari, F.; Lohse, M.; Usadel, B.; Kühn, C.; Bleiss, W.; Giavalisco, P.; Willmitzer, L.; et al. RNA Interference of LIN5 in Tomato Confirms Its Role in Controlling Brix Content, Uncovers the Influence of Sugars on the Levels of Fruit Hormones, and Demonstrates the Importance of Sucrose Cleavage for Normal Fruit Development and Fertility. Plant Physiol. 2009, 150, 1204–1218. [Google Scholar] [CrossRef] [PubMed]
- Jin, Y.; Ni, D.-A.; Ruan, Y.-L. Posttranslational Elevation of Cell Wall Invertase Activity by Silencing Its Inhibitor in Tomato Delays Leaf Senescence and Increases Seed Weight and Fruit Hexose Level. Plant Cell 2009, 21, 2072–2089. [Google Scholar] [CrossRef]
- Braun, D.M.; Wang, L.; Ruan, Y.-L. Understanding and manipulating sucrose phloem loading, unloading, metabolism, and signalling to enhance crop yield and food security. J. Exp. Bot. 2014, 65, 1713–1735. [Google Scholar] [CrossRef] [PubMed]
- Tiessen, A.; Padilla, C.D. Subcellular compartmentation of sugar signaling: Links among carbon cellular status, route of sucrolysis, sink-source allocation, and metabolic partitioning. Front. Plant Sci. 2013, 3, 306. [Google Scholar] [CrossRef] [PubMed]
- Chen, L.-Q.; Qu, X.-Q.; Hou, B.-H.; Sosso, D.; Osorio, S.; Fernie, A.R.; Frommer, W.B. Sucrose Efflux Mediated by SWEET Proteins as a Key Step for Phloem Transport. Science 2012, 335, 207–211. [Google Scholar] [CrossRef] [PubMed]
- Eom, J.-S.; Chen, L.-Q.; Sosso, D.; Julius, B.T.; Lin, I.W.; Qu, X.-Q.; Braun, D.M.; Frommer, W.B. SWEETs, transporters for intracellular and intercellular sugar translocation. Curr. Opin. Plant Biol. 2015, 25, 53–62. [Google Scholar] [CrossRef] [PubMed]
- Feng, C.-Y.; Han, J.-X.; Han, X.-X.; Jiang, J. Genome-wide identification, phylogeny, and expression analysis of the SWEET gene family in tomato. Gene 2015, 573, 261–272. [Google Scholar] [CrossRef]
- Bezrutczyk, M.; Hartwig, T.; Horschman, M.; Char, S.N.; Yang, J.L.; Yang, B.; Frommer, W.B.; Sosso, D. Impaired phloe m loading in zmsweet13a,b,c sucrose transporter triple knock-out mutants in Zea mays. New Phytol. 2018, 218, 594–603. [Google Scholar] [CrossRef]
- Julius, B.T.; Leach, K.A.; Tran, T.M.; Mertz, R.A.; Braun, D.M. Sugar Transporters in Plants: New Insights and Discoveries. Plant Cell Physiol. 2017, 58, 1442–1460. [Google Scholar] [CrossRef]
- Patrick, J.W. Phloem unloading: Sieve element unloading and post-sieve element transport. Annu. Rev. Plant Biol. 1997, 48, 191–222. [Google Scholar] [CrossRef]
- Ayre, B.G. Membrane-Transport Systems for Sucrose in Relation to Whole-Plant Carbon Partitioning. Mol. Plant 2011, 4, 377–394. [Google Scholar] [CrossRef]
- Osorio, S.; Ruan, Y.-L.; Fernie, A.R. An update on source-to-sink carbon partitioning in tomato. Front. Plant Sci. 2014, 5, 516. [Google Scholar] [CrossRef]
- Kühn, C.; Grof, C.P.L. Sucrose transporters of higher plants. Curr. Opin. Plant Biol. 2010, 13, 287–297. [Google Scholar] [CrossRef] [PubMed]
- Lin, I.W.; Sosso, D.; Chen, L.-Q.; Gase, K.; Kim, S.-G.; Kessler, D.; Klinkenberg, P.M.; Gorder, M.K.; Hou, B.-H.; Qu, X.-Q.; et al. Nectar secretion requires sucrose phosphate synthases and the sugar transporter SWEET9. Nature 2014, 508, 546–549. [Google Scholar] [CrossRef]
- Chen, L.-Q.; Lin, I.W.; Qu, X.-Q.; Sosso, D.; McFarlane, H.E.; Londoño, A.; Samuels, A.L.; Frommer, W.B. A Cascade of Sequentially Expressed Sucrose Transporters in the Seed Coat and Endosperm Provides Nutrition for the Arabidopsis Embryo. Plant Cell 2015, 27, 607–619. [Google Scholar] [CrossRef] [PubMed]
- Yang, J.; Luo, D.; Yang, B.; Frommer, W.B.; Eom, J.-S. SWEET 11 and 15 as key players in seed filling in rice. New Phytol. 2018, 218, 604–615. [Google Scholar] [CrossRef] [PubMed]
- Krügel, U.; Kühn, C. Post-translational regulation of sucrose transporters by direct protein-protein interactions. Front. Plant Sci. 2013, 4, 237. [Google Scholar] [CrossRef]
- Rouina, H.; Tseng, Y.H.; Nataraja, K.N.; Uma, S.R.; Oelmüller, R. Arabidopsis restricts sugar loss to a colonizing trichoderma harzianum strain by downregulating SWEET11 and -12 and upregulation of SUC1 and SWEET2 in the roots. Microorganisms 2021, 9, 1246. [Google Scholar] [CrossRef]
- Carpenter, S.C.D.; Mishra, P.; Ghoshal, C.; Dash, P.K.; Wang, L.; Midha, S.; Laha, G.S.; Lore, J.S.; Kositratana, W.; Singh, N.K.; et al. A Strain of an Emerging Indian Xanthomonas oryzae pv. oryzae Pathotype Defeats the Rice Bacterial Blight Resistance Gene xa13 Without Inducing a Clade III SWEET Gene and Is Nearly Identical to a Recent Thai Isolate. Front. Microbiol. 2018, 9, 2703. [Google Scholar] [CrossRef]
- Pierre, G.; Martin, K.; Timo, E.; Uwe, S.; Christian, K.; Voll, L.M. Sugar accumulation in leaves of Arabidopsis sweet11/sweet12 double mutants enhances priming of the salicylic acid-mediated defense response. Front. Plant Sci. 2017, 8, 1378. [Google Scholar]
- Yao, L.; Ding, C.; Hao, X.; Zeng, J.; Yang, Y.; Wang, X.; Wang, L. CsSWEET1a and CsSWEET17 Mediate Growth and Freezing Tolerance by Promoting Sugar Transport across the Plasma Membrane. Plant Cell Physiol. 2020, 61, 1669–1682. [Google Scholar] [CrossRef]
- Zhang, X.; Feng, C.; Wang, M.; Li, T.; Liu, X.; Jiang, J. Plasma membrane-localized SlSWEET7a and SlSWEET14 regulate sugar transport and storage in tomato fruits. Hortic. Res. 2021, 8, 1–16. [Google Scholar] [CrossRef] [PubMed]
- Ko, H.-Y.; Ho, L.-H.; Neuhaus, H.E.; Guo, W.-J. Transporter SlSWEET15 unloads sucrose from phloem and seed coat for fruit and seed development in tomato. Plant Physiol. 2021, 187, 2230–2245. [Google Scholar] [CrossRef]
- Guo, M.; Zhang, Y.L.; Meng, Z.J.; Jiang, J. Optimization of factors affecting Agrobacterium-mediated transformation of Micro-Tom tomatoes. Genet. Mol. Res. 2012, 11, 661–671. [Google Scholar] [CrossRef]
- McCurdy, D.W.; Dibley, S.; Cahyanegara, R.; Martin, A.; Patrick, J.W. Functional Characterization and RNAi-Mediated Suppression Reveals Roles for Hexose Transporters in Sugar Accumulation by Tomato Fruit. Mol. Plant 2010, 3, 1049–1063. [Google Scholar] [CrossRef]
- Hao, J.H.; Li, T.L.; Meng, S.D.; Zhao, B.; Sun, L.P. Effects of night low temperature on sugar accumulation and sugar-metabolizing enzyme activities in melon fruit. Sci. Agric. Sin. 2009, 42, 3592–3599. [Google Scholar]
- Martin, M.L.; Lechner, L.; Zabaleta, E.J.; Salerno, G.L. A mitochondrial alkaline/neutral invertase isoform (A/N-InvC) functions in developmental energy demanding processes in Arabidopsis. Planta 2013, 237, 813–822. [Google Scholar] [CrossRef]
- Kim, D.; Park, S.Y.; Chung, Y.; Park, J.; Lee, S.; Lee, T.-K. Biochemical Characterization of Soluble Acid and Alkaline Invertases from Shoots of Etiolated Pea Seedlings. J. Integr. Plant Biol. 2010, 52, 536–548. [Google Scholar] [CrossRef]
- Le Hir, R.; Spinner, L.; Klemens, P.A.W.; Chakraborti, D.; de Marco, F.; Vilaine, F.; Wolff, N.; Lemoine, R.; Porcheron, B.; Géry, C.; et al. Disruption of the Sugar Transporters AtSWEET11 and AtSWEET12 Affects Vascular Development and Freezing Tolerance in Arabidopsis. Mol. Plant 2015, 8, 1687–1690. [Google Scholar] [CrossRef]
- Chen, L.-Q.; Hou, B.-H.; Lalonde, S.; Takanaga, H.; Hartung, M.L.; Qu, X.-Q.; Guo, W.-J.; Kim, J.-G.; Underwood, W.; Chaudhuri, B.; et al. Sugar transporters for intercellular exchange and nutrition of pathogens. Nature 2010, 468, 527–532. [Google Scholar] [CrossRef]
- Koch, K. Sucrose metabolism: Regulatory mechanisms and pivotal roles in sugar sensing and plant development. Curr. Opin. Plant Biol. 2004, 7, 235–246. [Google Scholar] [CrossRef] [PubMed]
- Brown, M.M.; Hall, J.L.; Ho, L.C. Sugar uptake by protoplasts isolated from tomato fruit tissues during various stages of fruit growth. Physiol. Plantarum. 2006, 101, 533–539. [Google Scholar] [CrossRef]
- Yu, S.M.; Lo, S.F.; Ho, T.H.D. Source-sink communication: Regulated by hormone, nutrient, and stress cross-signaling. Trends Plant Sci. 2015, 20, 844–857. [Google Scholar] [CrossRef]
- Chen, L. SWEET sugar transporters for phloem transport and pathogen nutrition. New Phytol. 2014, 201, 1150–1155. [Google Scholar] [CrossRef]

Publisher’s Note: MDPI stays neutral with regard to jurisdictional claims in published maps and institutional affiliations. |
© 2022 by the authors. Licensee MDPI, Basel, Switzerland. This article is an open access article distributed under the terms and conditions of the Creative Commons Attribution (CC BY) license (https://creativecommons.org/licenses/by/4.0/).
Share and Cite
Sun, J.; Feng, C.; Liu, X.; Jiang, J. The SlSWEET12c Sugar Transporter Promotes Sucrose Unloading and Metabolism in Ripening Tomato Fruits. Horticulturae 2022, 8, 935. https://doi.org/10.3390/horticulturae8100935
Sun J, Feng C, Liu X, Jiang J. The SlSWEET12c Sugar Transporter Promotes Sucrose Unloading and Metabolism in Ripening Tomato Fruits. Horticulturae. 2022; 8(10):935. https://doi.org/10.3390/horticulturae8100935
Chicago/Turabian StyleSun, Jiaqi, Chaoyang Feng, Xin Liu, and Jing Jiang. 2022. "The SlSWEET12c Sugar Transporter Promotes Sucrose Unloading and Metabolism in Ripening Tomato Fruits" Horticulturae 8, no. 10: 935. https://doi.org/10.3390/horticulturae8100935
APA StyleSun, J., Feng, C., Liu, X., & Jiang, J. (2022). The SlSWEET12c Sugar Transporter Promotes Sucrose Unloading and Metabolism in Ripening Tomato Fruits. Horticulturae, 8(10), 935. https://doi.org/10.3390/horticulturae8100935

